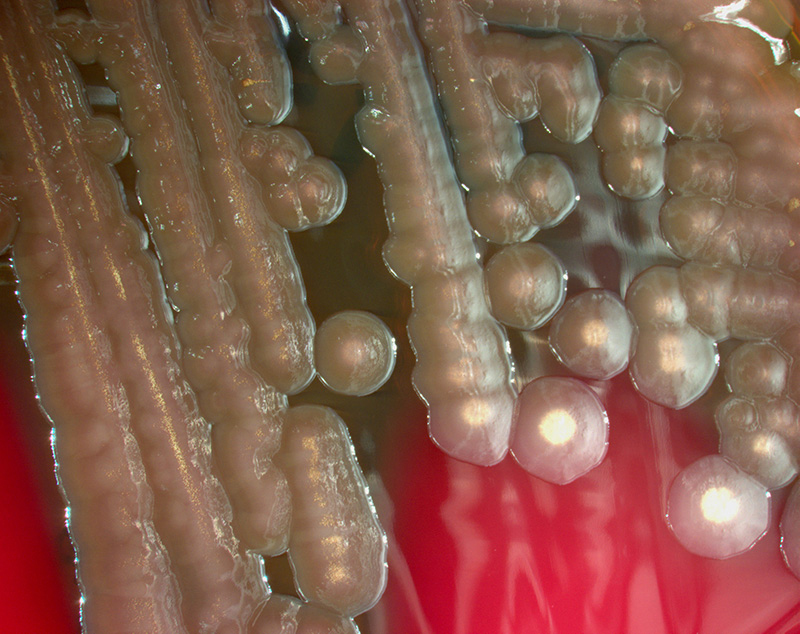

♦ What is cholera?
Cholera is an infection of the small intestine by some strains of the bacterium Vibrio cholerae.
Cholera is caused by a number of types of Vibrio cholerae, with some types producing more severe disease than others. It is spread mostly by unsafe water and unsafe food that has been contaminated with human feces containing the bacteria. Undercooked seafood is a common source. Humans are the only animal affected.
Risk factors for the disease include poor sanitation, not enough clean drinking water, and poverty. There are concerns that rising sea levels will increase rates of disease.
♦ Signs and symtoms
The primary symptoms of cholera are profuse diarrhea and vomiting of clear fluid. These symptoms usually start suddenly, half a day to five days after ingestion of the bacteria. The diarrhea is frequently described as "rice water" in nature and may have a fishy odor. An untreated person with cholera may produce 10 to 20 litres of diarrhea a day. Severe cholera, without treatment, kills about half of affected individuals. If the severe diarrhea is not treated, it can result in life-threatning dehydration and electrolyte imbalances.
Estimates of the ratio of asymptomatic to symptomatic infections have ranged from 3 to 100. Cholera has been nicknamed the "blue death" because a person's skin may turn bluish-gray from extreme loss of fluids.
Fever is rare and should raise suspicion for secondary infection. Patients can be lethargic, and might have sunken eyes, dry mouth, cold clammy skin, or wrinkled hands and feet. Blood pressure drops due to dehydration, peripheral pulse is rapid and thready, and urine output decreases with time. Muscle cramping and weakness, altered consciousness, seizures, or even coma due to electrolyte imbalances are common, especially in children.
♦ Cause
When ingested, V. cholerae can cause cholera.
♦ Transmission
Cholera has been found in two animal populations: shellfish and plankton.
Transmission is usually through the fecal-oral route of contaminated food or water caused by poor sanitation. Most cholera cases in developed countries are a result of transmission by food, while in the developing world it is more often water. Food transmission can occur when people harvest seafood such as oysters in waters infected with sewage, as Vibrio cholerae accumulates in planktonic crustaceans and the oysters eat the zooplankton.
Both toxic and non-toxic strains exist. Non-toxic strains can acquire toxicity through a temperate bacteriophage.
♦ Diagnosis
A rapid dipstick test is available to determine the presence of V. cholera. In those samples that test positive, further testing should be done to determine antibiotic resistance. In epidemic situations, a clinical diagnosis may be made by taking a patient history and doing a brief examination. Treatment is usually started without or before confirmation by laboratory analysis.
Stool and swab samples collected in the acute stage of the disease, before antibiotics have been administered, are the most useful specimens for laboratory diagnosis. If an epidemic of cholera is suspected, the most common causative agent is V. cholerae O1.
If V. cholerae serogroup O1 is not isolated, the laboratory should test for V. cholerae O139. However, if neither of these organisms is isolated, it is necessary to send stool specimens to a reference laboratory. Infection with V. cholerae O139 should be reported and handled in the same manner as that caused by V. cholerae O1. The associated diarrheal illness should be referred to as cholera and must be reported.
♦ Prevention
Prevention methods against cholera include improved sanitation and access to clean water. Cholera vaccines that are given by mouth provide reasonable protection for about six months. They have the added benefit of protecting against another type of diarrhea caused by E. coli. The primary treatment is oral rehydration therapy—the replacement of fluids with slightly sweet and salty solutions. Rice-based solutions are preferred. Zinc supplementation is useful in children. In severe cases, intravenous fluids, such as Ringer's lactate, may be required, and antibiotics may be beneficial. Testing to see which antibiotic the cholera is susceptible to can help guide the choice.
♦ Antibiotic resistance
In many areas of the world, antibiotic resistance is increasing within cholera bacteria. In Bangladesh, for example, most cases are resistant to tetracycline, trimethoprim-sulfamethoxazole, and erythromycin. Rapid diagnostic assay methods are available for the identification of multi-drug resistant cases. New generation antimicrobials have been discovered which are effective against cholera bacteria in in vitro studies.
♦ Treatment
Antibiotic treatments for one to three days shorten the course of the disease and reduce the severity of the symptoms. Use of antibiotics also reduces fluid requirements. People will recover without them, however, if sufficient hydration is maintained. The World Health Organization only recommends antibiotics in those with severe dehydration.
Doxycycline is typically used first line, although some strains of V. cholerae have shown resistance. Testing for resistance during an outbreak can help determine appropriate future choices. Other antibiotics proven to be effective include cotrimoxazole, erythromycin, tetracycline, chloramphenicol, and furazolidone.
Fluoroquinolones, such as ciprofloxacin, also may be used, but resistance has been reported.
Antibiotics improve outcomes in those who are both severely and not severely dehydrated. Azithromycin and tetracycline may work better than doxycycline or ciprofloxacin.
♦ Prognosis
If people with cholera are treated quickly and properly, the mortality rate is less than 1%; however, with untreated cholera, the mortality rate rises to 50–60%.
For certain genetic strains of cholera, such as the one present during the 2010 epidemic in Haiti and the 2004 outbreak in India, death can occur within two hours of becoming ill.
♦ Epidemiology
Cholera affects an estimated 3–5 million people worldwide and causes 28,800–130,000 deaths a year. Although it is classified as a pandemic as of 2010, it is rare in the developed world. Children are mostly affected. Cholera occurs as both outbreaks and chronically in certain areas. Areas with an ongoing risk of disease include Africa and Southeast Asia. The risk of death among those affected is usually less than 5% but may be as high as 50%. No access to treatment results in a higher death rate. Descriptions of cholera are found as early as the 5th century BC in Sanskrit. Seven large outbreaks have occurred over the last 200 years with millions of deaths.